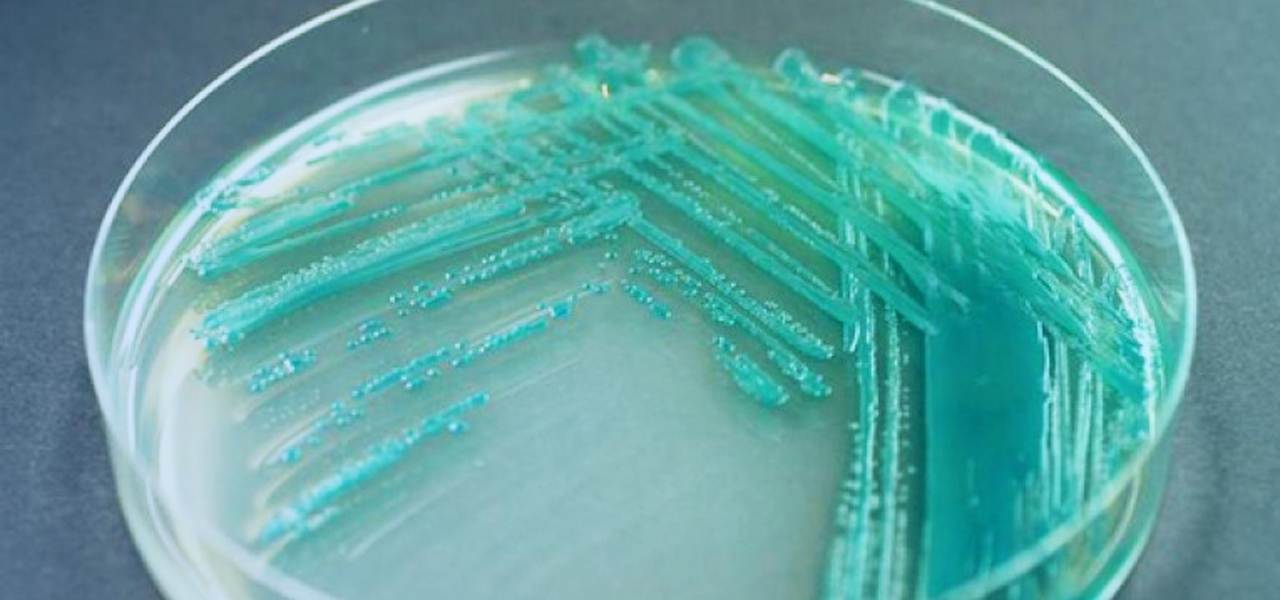

Российские учёные из Институтов биофизики и белка РАН изобрели противомикробные пептидные комплексы для борьбы с бактериями, устойчивыми к воздействию антибиотиков.
ferra.ru2021-11-18 15:45
Российские учёные из Институтов биофизики и белка РАН изобрели противомикробные пептидные комплексы для борьбы с бактериями, устойчивыми к воздействию антибиотиков.
ferra.ru
Российские и китайские исследователи изучили железомарганцевые корки на подводных горах в центре Императорской гряды на севере Тихого океана. Экспедиция показала, что эти корки содержат ценные металлы: свинец, кобальт, молибден, вольфрам, никель, редкоземельные элементы и иттрий. ferra.ru »
2025-10-18 22:35
Новые научные данные показывают, что птеростильбен утолщает эпидермис благодаря укреплению коллагеновых и эластичных волокон, которые содержат эластин. Для этого участники в течение 28 дней наносили экспериментальную эмульсию с этим веществом только на одну половину лица. ferra.ru »
2025-10-03 18:45
Исследователи из Токийского университета впервые смогли проследить, как формируются золотые нанокластеры на самых ранних этапах. В процессе они обнаружили необычную вытянутую структуру, которую назвали «золотые квантовые иглы». ferra.ru »
2025-09-07 14:15
Российские и вьетнамские биологи обнаружили в тропических лесах Вьетнама три новых вида зелёных водорослей, которые накапливают ценные жирные кислоты — омега-3 и омега-6. Эти вещества необходимы для здоровья человека, особенно для сердца, мозга и иммунитета. ferra.ru »
2025-08-07 15:20
В России разработали гибкие пластины, которые светятся в видимом спектре при воздействии рентгеновских лучей ferra.ru »
2025-06-04 21:04
Большинство рыжих кошек на самом деле имеют одну генетическую мутацию, которая их делает рыжими. Эксперты определили делецию ДНК, которая заставляет пигментные клетки производить жёлто-красный цвет вместо стандартного коричнево-чёрного. ferra.ru »
2025-05-20 00:00
Фталаты — это группа химикатов, которые содержатся в шампунях, лосьонах, упаковке пищевых продуктов, медицинских принадлежностях. Учёные считают, что они могут быть связаны со смертностью от болезней сердца. ferra.ru »
2025-05-16 00:00
Блокчейн начнут использовать в медицине для подтверждения подлинности лекарств ferra.ru »
2025-05-12 20:50
Новое исследование даёт надежду взрослым, которые страдают аллергией на арахис. Всё потому, что у них, как оказалось, может развиться толерантность к этим орехам в течение нескольких недель. ferra.ru »
2025-04-25 16:30
В Центре научной коммуникации МФТИ сообщили, что российские и зарубежные ученые предложили новый способ изучения клеточных рецепторов, который может заметно ускорить разработку лекарств. Речь идёт о семиспиральных белках — особых молекулах, встроенных в оболочку клеток и отвечающих за передачу сигнала внутрь клетки при взаимодействии с внешними веществами. ferra.ru »
2025-04-24 11:40
Исследователи из AIRI доказали, что нейросети могут значительно более точно предсказывать свойства материалов, если учитывать симметрию кристаллических структур при обучении. ferra.ru »
2025-04-16 10:00
Многие пользуются умными часами, чтобы отслеживать показатели здоровья. По данным нового исследования, расчёт ежедневной частоты сердечных сокращений на шаг (DHRPS) при помощи данных со смарт-часов помогает узнать больше о состоянии сердца. ferra.ru »
2025-04-07 15:45
Палеогенетики из Германии, Италии, Ливии и Нидерландов во главе с Йоханнесом Краузе из Института эволюционной антропологии Общества Макса Планка обнаружили на территории современной Ливии ранее неизвестную древнюю популяцию людей, существовавшую в период Зелёной Сахары около 7200-6300 лет назад. ferra.ru »
2025-04-03 17:32
Более 70 лет так называемые вечные химикаты использовались для создания вещей вокруг нас. К ним относятся антипригарная посуда, ткани, упаковки для продуктов и пр. Эти вещества эксперты связывали с серьёзными последствиями для здоровья. В том числе с несколькими видами рака. ferra.ru »
2025-03-29 00:00
Исследователи из Бельгии, Австралии и Гонконга придумали, как сделать электричество без привычных батареек. Они использовали крошечные пластиковые шарики, чтобы создать энергию с помощью трения — это называется трибоэлектрификация. ferra.ru »
2025-03-17 14:53
В ходе нового исследования эксперты изучили данные о более 200 собаках. Это позволило им найти ключевые связи между ожирением и у людей и у псов. ferra.ru »
2025-03-09 13:30
Учёные из Швейцарской высшей технической школы Цюриха и Калифорнийского технологического института в статье для журнала Scientific Reports сообщили о своём «ошеломительном» открытии: авторы рассказали об обнаружении «невозможных» гигантских структур на дне Тихого океана. ferra.ru »
2025-01-15 08:15
Учёные МИСиС, совместно с зарубежными коллегами разработали технологию получения ценного строительного материала при очистке воды ferra.ru »
2024-12-12 23:16
Ученые из Московской сельскохозяйственной академии имени К.А. Тимирязева придумали, как снизить пожароопасность торфяников ferra.ru »
2024-11-24 22:20
Учёные нашли лёд на фото со спутника одного из кратеров южного полюса Луны ferra.ru »
2024-11-22 00:32
Российские учёные создали устройство для изучения качеств материалов ferra.ru »
2024-11-19 20:57
Российские учёные изучили методы измерения объёмов месторождений и нашли наиболее точный ferra.ru »
2024-11-15 01:17
Учёные приблизили создание квантовых компьютеров будущего ferra.ru »
2024-11-05 21:56
Ученые обнаружили, что область CA2 гиппокампа у мышей играет решающую роль в кодировании социальных воспоминаний, особенно связанных с угрозами. Это открытие может пролить свет на такие расстройства человека, как социальная тревога и посттравматическое стрессовое расстройство (ПТСР). ferra.ru »
2024-10-18 10:30
Российские, белорусские и китайские учёные разработали технологию внедрения сенсоров из нанотрубок в полимерные материалы ferra.ru »
2024-09-18 19:33
В России придумали, как упростить процедуру исследования воды на загрязнения ferra.ru »
2024-09-12 21:01
Новый научный обзор проводился по заказу Всемирной организации здравоохранения (ВОЗ). 11 экспертов из 10 стран проанализировали 5 тысяч исследований, которые были опубликованы в 1994—2022 годы. Окончательный анализ можно посмотреть в журнале Environmental International. ferra.ru »
2024-09-06 01:30
Ученые из Университета Альберты разработали метод, позволяющий нейросетям сохранять способность к обучению при продолжительном использовании. В своем исследовании, опубликованном в журнале Nature, учёные выявили проблему «катастрофического забывания», когда искусственный интеллект теряет способность выполнять ранее освоенные задачи при обучении на новых данных. ferra.ru »
2024-08-22 22:35
Замечаете, что иногда отключаетесь на середине предложения, теряясь в мире собственных мыслей? Если так происходит постоянно, то у вас может быть менее распространённое расстройство внимания — синдром когнитивной отстранённости (CDS). ferra.ru »
2024-08-04 06:45
Учёные из Антарктической службы Великобритании (BAS) обнаружили неизвестный ранее механизм ускоренного таяния ледниковых щитов у побережья Антарктиды и Гренландии, способствующий их сползанию в море. ferra.ru »
2024-06-29 00:45
Учёная-эколог Мишель Франсис из Стелленбосского университета в ЮАР в журнале Science of the Total Environment опубликовала статью о находке старейших на Земле термитников, возраст которых не менее 34 тысяч лет. ferra.ru »
2024-06-27 14:15
Российские учёные, совместно с коллегами из Китая, нашли вероятное объяснение необычного магнитного поля Урана и Нептуна ferra.ru »
2024-06-01 23:26
Результаты нового исследования показали, что если измельчить лист с оскорблениями и выбросить его, то это уменьшит чувство гнева. Причём почти полностью. Это было действительно неожиданно, признались сами учёные. ferra.ru »
2024-04-11 07:30
Замечали, что иногда, даже если вы сытно поели, вам вскоре хочется чем-нибудь перекусить? Психологи Калифорнийского университета в Лос-Анджелесе нашли ответ на вопрос, почему так происходит. ferra.ru »
2024-03-22 02:15
Жировая болезнь печени — состояние, связанное как с перееданием, так и с голоданием, — может привести к серьезным повреждениям печени. Новое исследование с участием пещерных рыб открывает путь к пониманию этого состояния и потенциальной разработке методов лечения. ferra.ru »
2024-03-20 18:00
80% мужчин сталкиваются с облысением по мужскому типу. Однако до недавнего времени исследователям мало было известно о том, как можно замедлить, остановить и обратить вспять этот процесс. ferra.ru »
2024-03-11 02:15
В мире начал набирать обороты новый вариант коронавируса JN.1. Согласно информации Центра по контролю и профилактике заболеваний Великобритании, заболеваемость новым вариантом JN.1 кратно увеличилась в их стране, а также во Франции, в США, Португалии, Исландии, Испании. ferra.ru »
2024-01-04 14:23
Учёные из МГУ придумали, как остановить передачу информации внутри грибной колонии. Это поможет в борьбе с грибковыми инфекциями ferra.ru »
2023-11-24 22:36
Исследователи из Университета Калифорнии в Лос-Анджелесе сделали прорыв в области охлаждения процессоров. ferra.ru »
2023-11-15 13:30
В ходе нового исследования выяснилось, что использование предупреждающих надписей на мясных продуктах может улучшить здоровье населения и сократить выбросы углекислого газа. Полученные результаты были опубликованы в журнале Appetite. ferra.ru »
2023-11-02 04:30
Учёные провели масштабное исследование, в котором анализировались данные из 761 сообщества в 35 странах мира. ferra.ru »
2023-10-06 07:03
Микропластик, который мы часто ассоциируем с загрязнением мировых океанов, теперь обнаружен даже в самых отдалённых уголках планеты — в арктическом воздухе. ferra.ru »
2023-08-18 08:25
Одна из самых древних эволюционных загадок, которая ещё и стала популярной среди обычных людей — это вопрос: а что было раньше, яйцо или курица? ferra.ru »
2023-06-15 20:40
Новое исследование показывает, что уровень жира в мышцах тела может указывать на вероятность когнитивного ухудшения с возрастом. ferra.ru »
2023-06-09 07:43
Совсем скоро мы можем стать свидетелями революции в борьбе с облысением благодаря новому исследованию из Северо-Западного университета. ferra.ru »
2023-06-06 19:33
Каждая третья планета вокруг красных карликов, самых многочисленных звёзд в нашей галактике, потенциально пригодна для жизни. ferra.ru »
2023-05-31 23:05
Китайские археологи обнаружили подземный бункер, который использовал японский «Отряд 731» во время Второй мировой войны. ferra.ru »
2023-05-31 22:44
Новое исследование показало, что у Земли есть новая луна — или по крайней мере, «квази-луна». ferra.ru »
2023-05-29 21:40
Учёные из Университета Небраски провели исследование, в ходе которого выяснили, как отличается связь между хозяином и спасённой собакой от связи между хозяином и собакой, которая не испытала стрессовых ситуаций в прошлом. ferra.ru »
2023-05-23 08:28
Несмотря на удивительную способность китов жить до 200 лет и сохранять здоровье несмотря на огромное количество клеток в их теле, учёные все ещё мало что знают о механизмах их устойчивости к раку. ferra.ru »
2023-05-22 21:38